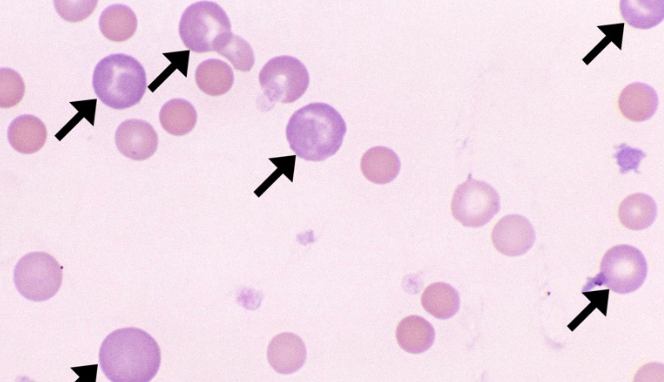
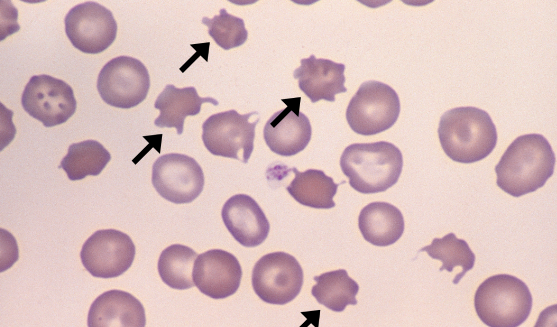
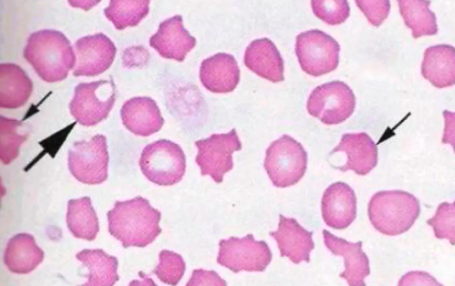
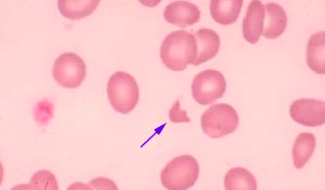
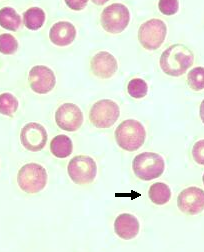
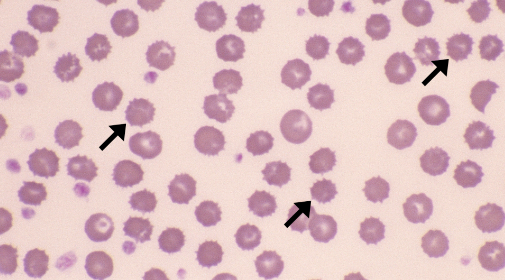
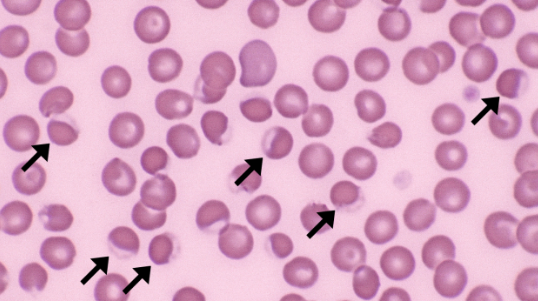
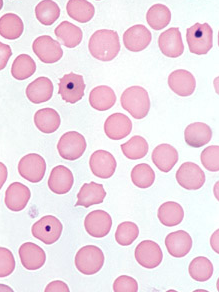
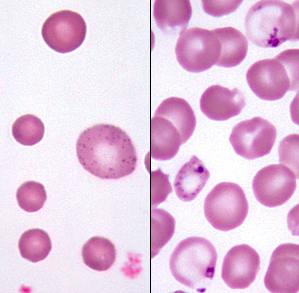
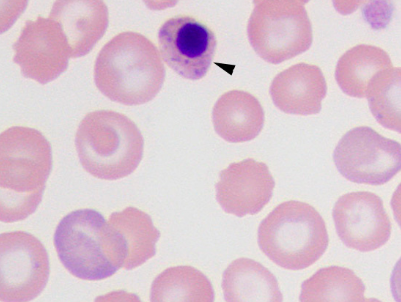
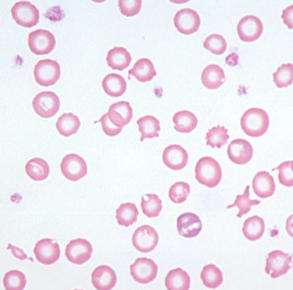
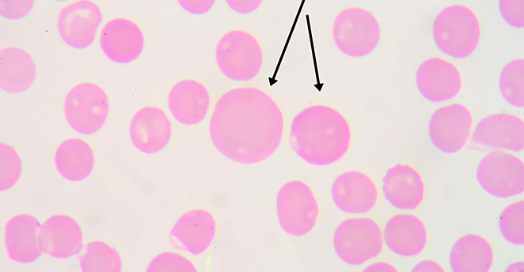
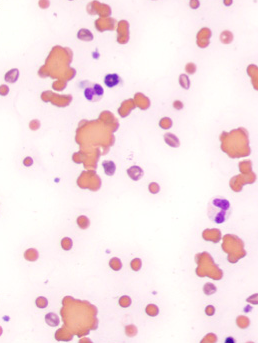
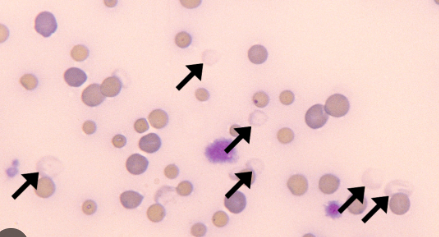

polychromatophils
indicative of regenerative response
acanthocytes
indicative of change in lipid composition in the cell membrane OR fragmentation injury
keratocyte
indiciative of mechanical injury/fragmentation injury/shearing of RBCs, often accompanied by schizocytes
schizocyte
indicative of mechanical red cell injury/fragmentation/shearing
spherocyte
indicative of IMHA
echinocytes
usually an artifact of drying, usually no clinical relevance
eccentrocytes
indicative of oxidative damage

heinz body
indicative of oxidative damage
howell-jolly bodies
remanant of the RBC nucelus, may be indicative of a regenerative response
basophilic stippling
aggregation of RNA, indicative of a regernative response or lead poisoning
metarubricyte
nucelated RBC, indicative of regernative response
hypochromasia
indicative of an iron deficiency anemia, copper deficiency, inherited condition, lack of hemoglobin production
macrocyte
indicative of regeneration
agglutination, indicative of IMHA
ghost cells
indicative of intravascular hemolysis


